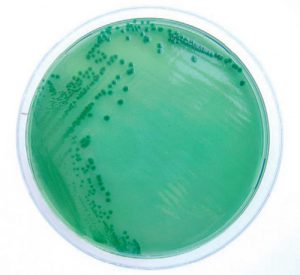

Infezione da Vibrio parahaemolyticus
Tra le diverse forme di gastroenterite batterica, l’infezione da Vibrio parahaemolyticus tende a colpire quei soggetti che abitualmente consumano prodotti ittici crudi o poco cotti, in particolare i frutti di mare contaminati. Di fatto questo germe Gram negativo viene isolato in diversi prodotti ittici, anche se non tutti i ceppi sono patogeni, i ceppi patogeni presentano uno oppure entrambe le emolisine TDH (termostabile emolisina diretta) e TRH (emolisina termostabile-correlati); nello specifico hanno un comportamento da patogeno quelli che lisano i globuli rossi del sangue (ceppi Kanagawa positivi), la TDH è la tossina che provoca la lisi dei globuli rossi e che può attaccare le cellule intestinali. Questa forma di gastroenterite batterica viene scatenata a causa del consumo di frutti di mare crudi o frutti di mare cotti contaminati con il prodotto grezzo, attraverso una cottura e refrigerazione corretta si riducono i rischi di infezione da parte del patogeno.
Sintomi principali
L’ingestione di grandi quantità di patogeni contenuti nei prodotti ittici, determina la severità dei sintomi, l’infezione veicolata dal batterio Vibrio parahaemolyticus determina nel paziente delle manifestazioni alquanto comuni nel contesto patologico delle gastroenterite quali: dolori addominali, nausea, vomito, diarrea, febbre; in genere i disturbi si risolvono nel giro di meno di una settimana. L’entità dei sintomi è lieve, se il soggetto è in buone condizioni, possono sorgere delle complicanze nei soggetti con sistemi immunitari deboli, il questo caso il focus infettivo può spostarsi nel sistema circolatorio potendo scatenare delle gravi forme di setticemia se il paziente è debilitato da condizioni patologiche quali: cancro, AIDS, diabete, malattie epatiche, malattie renali. La gastroenterite Vibrio parahaemolyticus-associata di solito ha un decorso lieve o moderato, nei casi più severi può essere necessaria l’ospedalizzazione oppure il trattamento antibiotico per debellare il patogeno responsabile dell’infezione. Questo Gram negativo oltre ad essere responsabile di una malattia gastrointestinale di origine alimentare, può anche provocare l’insorgenza di infezioni della ferita, le modalità di contagio nell’uomo si verificano attraverso il contatto diretto di una ferita con dell’acqua marina o dell’acqua di estuario, la contaminazione può avvenire in presenza di ferite cutanee che possono venir esposte all’aggressione batterica durante la manipolazione di molluschi, crostacei ed altri prodotti ittici.